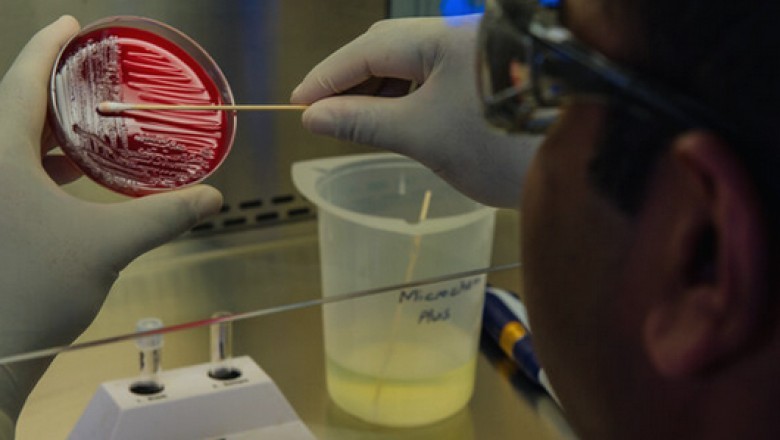
Bacoban Cleaner & Disinfectant Now Available In Canada | bacoban for the best

views
This patented solution tackles cleaning and disinfecting with a formula that not only kills 99.99% of bacteria, viruses and fungi, but also resolves the hygiene gap by creating a hygienic surface that prevents the growth of bacteria, mold, and mildew.
Bacoban is a cleaner and disinfectant that resolves the hygiene gap; use wherever superior hygiene is necessary, including plastic, ceramic, metal, stainless steel, porcelain, windows and electronics. Bacoban is authorized for sale by Health Canada.
What People Are Saying About Bacoban
This patented solution tackles cleaning and disinfecting with a formula that not only kills 99.99% of bacteria,viruses, and fungi but also resolves the hygiene gap by creating a hygienic surface that prevents the growth of bacteria, mold, and mildew. Bacoban 106 Cleaner & Disinfectant Spray
Exposure to certain chemicals can cause irritation to the eyes, mouth, lungs, and skin. Individuals with asthma or other respiratory problems are particularly susceptible. Disinfecting and Cleaning Wipes canada
Quick Links
- About
- Products Disinfecting and Cleaning Wipes bcoban
- Research
- Industry Sectors
Available From Coast to Coast
canadian Disinfectant Cleaner This patented solution tackles cleaning and disinfecting with a formula that not only kills 99.99% of bacteria, viruses, and fungi, but also resolves the hygiene gap by creating a hygienic surface that prevents the growth of bacteria, mold, and mildew. Cleaner & Disinfectant canada
For more information regarding ,visit our website: https://bacoban.ca












